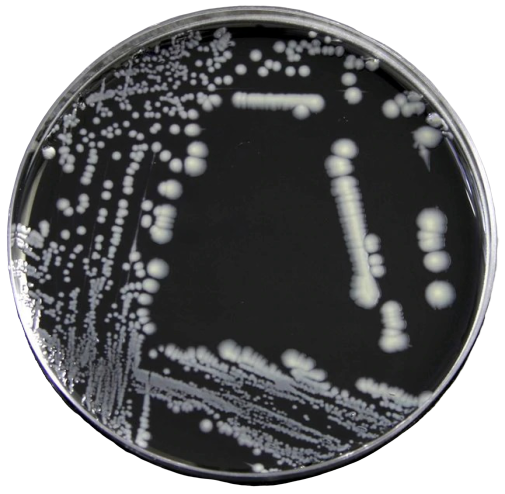
Legionella pneumophila colonies in BCYE agar - Legionella pneumophilacolonies in BCYE agar(Image source: Thermofischer)

Legionella is a faintly staining gram-negative pleomorphic rod, responsible for causing Legionnaires‘ disease; a severe form of atypical pneumonia,andPontiac fever.
Legionellawas first recognized in 1976 after an outbreak of pneumonia at an American Legion convention in Philadelphia.
Mode of Transmission: Legionella pneumophila has only been found in aquatic systems preferably in warm waters like hot tubs, cooling towers, hot water tanks, large plumbing systems, and air conditioners. People get Legionnaires’ disease when they inhale water aerosol (a mist or vapor) containing the bacteria. It is NOT transmitted from person to person.
Legionella pneumophilacan infect and multiply within some species of free-living amoebae or withinbiofilms.
Pathogenesis
Legionella pneumophila is a facultative intracellular pathogen. Cell-mediated immunityplays an important host defense against Legionella pneumophila infection.

- After Legionella reach the lungs through aspiration or direct inhalation, it attaches to the respiratory mucosa. This attachment is mediated by bacterial type IV pili, heat-shock proteins, and a major outer protein.
- Macrophages and neutrophils are recruited in the infected site, and alveolar macrophages phagocytoselegionella by a coiling mechanism.
- Legionella evades intracellular killing by inhibiting phagosome-lysosome fusion.
- Organism replicates intracellularly.
High-risk individuals
- Old age (people older than 55 years of age)
- Smoking: smoking damages alveolar macrophages
- High alcohol intake
- Immunosuppressed patients (e.g., renal transplant recipients)
Symptoms
Pontiac fever is self-limited, flu-like, which lasts for 2-5 day and resolve without treatment. Symptoms of Legionnaires’ disease include high fever, chills, a cough, shortness of breath, muscle aches, and headaches. It causes severe pneumonia (multilobar consolidated pneumonia with inflammation and microabscesses) with considerable morbidity and mortality, especially in immunocompromised individuals.
LaboratoryDiagnosis
Legionnaires’ disease is difficult to diagnose because pneumonia caused by Legionella is not easily distinguished from other forms of pneumonia.
**Sample:**Sputum, bronchoalveolar lavage, bronchial washing, and pleural fluid.
Thegrading systemused for screening sputum for routine cultures isnot applicableto Legionnaires’ disease because the sputum is non-purulent and may appear bloody or watery.
1.Microscopy

Gram stain reveals numerous neutrophils but no organism as legionellae are poorly stained often missed or sometimes appears as faint pleomorphic gram-negative rods or coccobacilli. Organisms can be observed on histologic examinations of tissue sections using silver impregnation or Giemsa stain or fluorescent antibody.
2.Culture
Isolation of Legionella from sputum or sterile body fluids confirms the diagnosis. Culture is a highly sensitive and specific test method. As Legionellais a fastidiousorganism and requires increased iron and cysteine for growth, media containing iron and cysteine i.e., buffered charcoal yeast extract agar (BCYE) is used. Culture plates are incubated at 37°C in a 5% CO2 environment for 3-5 days.
Colonies are round with entire edge, glistening, convex, green, or pink iridescent, and have granular or speckled opalescence resembling ground glass.
Biochemical test characteristics
- Motile
- Catalase positive
- Oxidase negative
- Hippurate hydrolysis positive
There are 16 serogroups of Legionella pneumophila and serogroup 1 accounts for ≈84% of human infections worldwide.
3. Urine Antigen Test
Pneumonia caused by Legionella pneumophila is often diagnosed by demonstration of L. pneumophila serogroup 1 antigens in urine by radioimmunoassay, enzyme-linked immunosorbent assay (ELISA) or immunochromatography. Antigen in urine is detected 3 days after onset of symptoms and disappears over 2 months. It is a highly sensitive (>85%) and specific (>99%) test. Test performance is not affected by prior use of antibiotics.
4. Serological Test
Diagnosis can be made serologically by detecting a rise in antibody titer in the patient’s serum. Paired serum samples can be tested for a four-fold increase in antibody levels during acute and convalescent-phase specimens to confirm the diagnosis.
References and further reading
- Swanson, M. S., & Hammer, B. K. (2000). Legionella PneumophilaPathogenesis: A Fateful Journey from Amoebae to Macrophages. Annual Review of Microbiology, 54(1), 567–613.
- Tille, P. (2017). Bailey & Scott’s Diagnostic Microbiology (14 edition). Mosby.